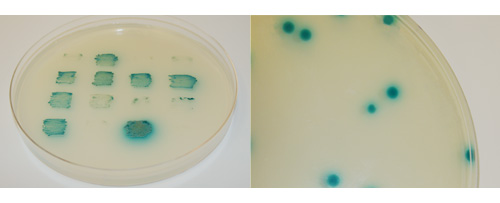
X-Alpha-Gal detects secreted alpha-galactosidase activity following a GAL4-based two-hybrid interactions in Y2HGold yeast patches and colonies

X-alpha-Gal for yeast two-hybrid studies
X-alpha-Gal is a chromogenic substrate for yeast galactosidase (MEL1) and is used for detecting GAL4-based yeast two-hybrid interactions directly on agar.
The X-alpha-Gal assay detects the activation of the yeast MEL1 gene, a GAL4-regulated gene used in yeast two-hybrid screening. MEL1 encodes the secreted enzyme alpha-galactosidase, which hydrolyzes colorless X-alpha-Gal into a blue end product. Yeast colonies that express alpha-galactosidase in response to a positive two-hybrid interaction turn blue when grown on media containing X-alpha-Gal.
X-Alpha-Gal detects secreted alpha-galactosidase activity following a GAL4-based two-hybrid interactions in Y2HGold yeast patches and colonies
X-Alpha-Gal detects secreted alpha-galactosidase activity following a GAL4-based two-hybrid interactions in Y2HGold yeast patches and colonies.
Yeast colonies that express alpha-galactosidase in response to a positive two-hybrid interaction turn blue when grown on media containing X-alpha-Gal

Yeast colonies that express alpha-galactosidase in response to a positive two-hybrid interaction turn blue when grown on media containing X-alpha-Gal.